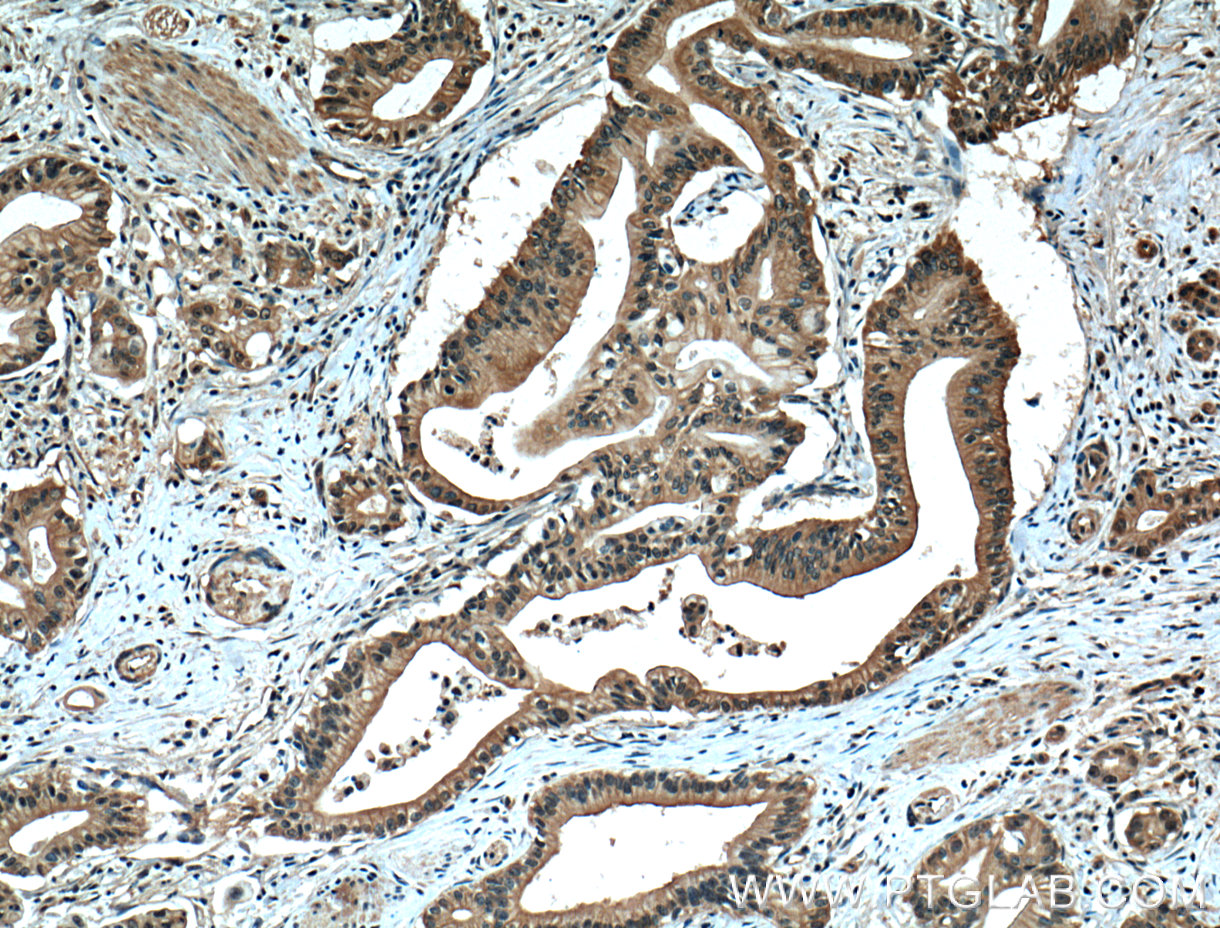

验证数据展示
经过测试的应用
| Positive WB detected in | HUVEC cells, HeLa cells, COLO 320 cells, A431 cells, LNCaP cells, HEK-293 cells, HepG2 cells |
| Positive IHC detected in | human pancreas cancer tissue, human prostate cancer tissue Note: suggested antigen retrieval with TE buffer pH 9.0; (*) Alternatively, antigen retrieval may be performed with citrate buffer pH 6.0 |
| Positive IF-P detected in | human breast cancer tissue |
| Positive IF/ICC detected in | MCF-7 cells, MDCK cells |
Freshly prepared samples are recommended.
推荐稀释比
| 应用 | 推荐稀释比 |
|---|---|
| Western Blot (WB) | WB : 1:1000-1:6000 |
| Immunohistochemistry (IHC) | IHC : 1:200-1:800 |
| Immunofluorescence (IF)-P | IF-P : 1:200-1:800 |
| Immunofluorescence (IF)/ICC | IF/ICC : 1:400-1:1600 |
| It is recommended that this reagent should be titrated in each testing system to obtain optimal results. | |
| Sample-dependent, Check data in validation data gallery. | |
产品信息
66452-1-Ig targets ZO-1 in WB, IHC, IF/ICC, IF-P, ELISA applications and shows reactivity with human, canine samples.
| 经测试应用 | WB, IHC, IF/ICC, IF-P, ELISA Application Description |
| 文献引用应用 | WB, IHC, IF |
| 经测试反应性 | human, canine |
| 文献引用反应性 | human, pig, canine |
| 免疫原 |
CatNo: Ag16454 Product name: Recombinant human ZO1 protein Source: e coli.-derived, PGEX-4T Tag: GST Domain: 1446-1748 aa of BC111712 Sequence: SLHIHSKGAHGEGNSVSLDFQNSLVSKPDPPPSQNKPATFRPPNREDTAQAAFYPQKSFPDKAPVNGTEQTQKTVTPAYNRFTPKPYTSSARPFERKFESPKFNHNLLPSETAHKPDLSSKTPTSPKTLVKSHSLAQPPEFDSGVETFSIHAEKPKYQINNISTVPKAIPVSPSAVEEDEDEDGHTVVATARGIFNSNGGVLSSIETGVSIIIPQGAIPEGVEQEIYFKVCRDNSILPPLDKEKGETLLSPLVMCGPHGLKFLKPVELRLPHCDPKTWQNKCLPGDPNYLVGANCVSVLIDHF 种属同源性预测 |
| 宿主/亚型 | Mouse / IgG1 |
| 抗体类别 | Monoclonal |
| 产品类型 | Antibody |
| 全称 | tight junction protein 1 (zona occludens 1) |
| 别名 | TJP1, ZO 1, Tight junction protein ZO-1, Tight junction protein ZO 1, Tight junction protein 1 |
| 计算分子量 | 1748 aa, 195 kDa |
| 观测分子量 | 230 kDa |
| GenBank蛋白编号 | BC111712 |
| 基因名称 | ZO-1 |
| Gene ID (NCBI) | 7082 |
| RRID | AB_2881821 |
| 偶联类型 | Unconjugated |
| 形式 | Liquid |
| 纯化方式 | Protein G purification |
| UNIPROT ID | Q07157 |
| 储存缓冲液 | PBS with 0.02% sodium azide and 50% glycerol, pH 7.3. |
| 储存条件 | Store at -20°C. Stable for one year after shipment. Aliquoting is unnecessary for -20oC storage. |
背景介绍
Tight junction (or zonula occludens) form the continuous intercellular barrier between epithelial and endothelial cells, which is required to separate tissue spaces and regulate selective movement of solutes across the epithelium and endothelium (PMID: 20066090). ZO-1 (also known as TJP1) is a peripheral membrane phosphoprotein located on the cytoplasmic face and is expressed in tight junctions of both epithelial and endothelial cells (PMID: 3528172). It binds the transmembrane proteins occludin and the claudins linking them to cytoskeletal actin (PMID: 17418867). ZO-1 belongs to a family of multidomain proteins known as the membrane-associated guanylate kinase homologs (MAGUKs). It is a pivotal tight junction protein and may be involved in signalling mechanisms regulating cell proliferation and differentiation (PMID: 22782886).
实验方案
| Product Specific Protocols | |
|---|---|
| IF protocol for ZO-1 antibody 66452-1-Ig | Download protocol |
| IHC protocol for ZO-1 antibody 66452-1-Ig | Download protocol |
| WB protocol for ZO-1 antibody 66452-1-Ig | Download protocol |
| Standard Protocols | |
|---|---|
| Click here to view our Standard Protocols |
发表文章
| Species | Application | Title |
|---|---|---|
ACS Nano Mind the Particle Rigidity: Blooms the Bioavailability via Rapidly Crossing the Mucus Layer and Alters the Intracellular Fate of Curcumin | ||
Sci Adv Astrocytic NDRG2-PPM1A interaction exacerbates blood-brain barrier disruption after subarachnoid hemorrhage | ||
Nat Commun An electrochemical biosensor for the detection of epithelial-mesenchymal transition. | ||
Cell Death Differ SARS-CoV-2 spike protein dictates syncytium-mediated lymphocyte elimination. | ||
ACS Appl Mater Interfaces Betaine-Based and Polyguanidine-Inserted Zwitterionic Micelle as a Promising Platform to Conquer the Intestinal Mucosal Barrier | ||
Int J Biol Macromol zwitterionic Pluronic analog-coated PLGA nanoparticles for oral insulin delivery |